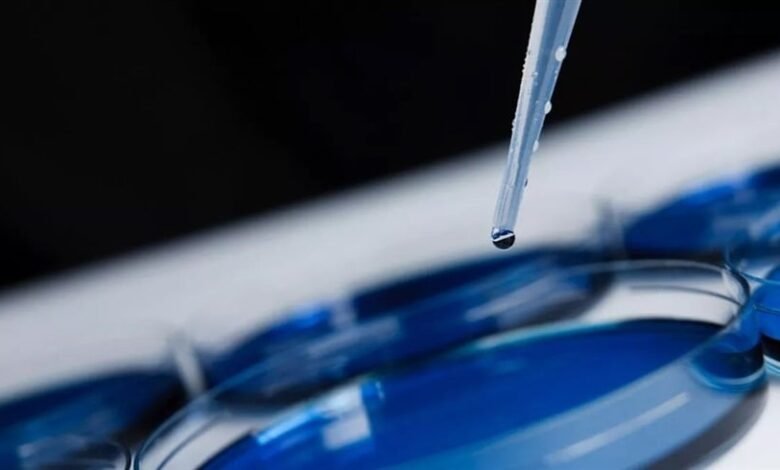

🩺صحة و جمال
اختراق علمي: علماء يحولون خلايا الجلد إلى بويضات لعلاج العقم
أنجز باحثون في جامعة أوريغون للصحة والعلوم إثباتاً فريداً لمفهوم علاج العقم عن طريق تحويل خلايا الجلد إلى بويضات قادرة على إنتاج أجنة بشرية مبكرة. لكن تطبيق هذا الإنجاز العلمي يتطلب سنوات إضافية من البحث.
Source link